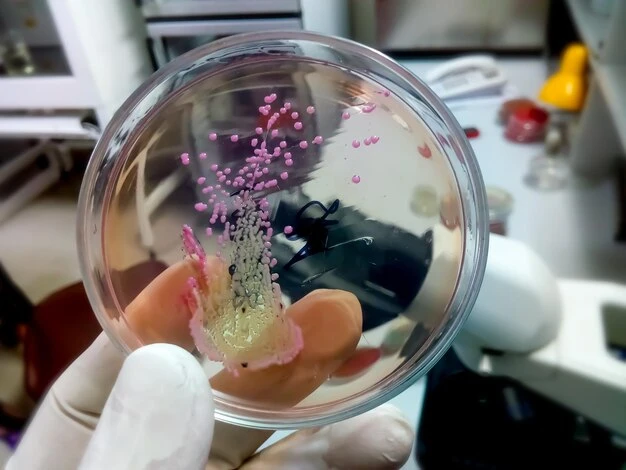
How Protein A Chromatography Resin Enhances Antibody Recovery

In the ever-evolving field of biopharmaceuticals, antibody purification is a crucial step in ensuring the quality and efficacy of therapeutic proteins. One of the most efficient and widely used methods for antibody recovery is Protein A chromatography. At Lytic Solutions, LLC, we specialize in providing high-quality Protein A Chromatography Resin that elevates the efficiency and precision of antibody purification. This article explores how Protein A Chromatography Resin enhances antibody recovery and why it is the gold standard for biopharmaceutical and research applications.
The Role of Protein A Chromatography Resin in Antibody Purification
Protein A is a bacterial-derived protein that binds with high affinity to the Fc region of immunoglobulin G (IgG). This selective binding capability allows Protein A Chromatography Resin to effectively isolate and purify antibodies from complex biological samples. The resin acts as a robust capture tool, enabling researchers to achieve high purity levels while maintaining the integrity and functionality of the antibodies.
Key Benefits of Protein A Chromatography Resin in Antibody Recovery
High Selectivity and Binding Efficiency
One of the primary reasons why Protein A Chromatography Resin is widely adopted in antibody purification is its exceptional selectivity. The resin ensures that only the target antibody is captured, reducing contamination from other proteins and impurities. This high specificity significantly improves recovery rates and enhances the overall yield of the purification process.
Improved Purity and Consistency
When working with monoclonal and polyclonal antibodies, purity is a top priority. Protein A Chromatography Resin provides a highly efficient purification process that results in antibodies with greater than 95% purity. This level of consistency is crucial for pharmaceutical applications, where therapeutic antibodies must meet strict regulatory standards.
Scalability for Industrial and Research Applications
Whether you are conducting small-scale laboratory research or large-scale industrial production, Protein A Chromatography Resin offers flexibility in scale-up operations. Its adaptability allows for seamless transitions from research and development to commercial manufacturing, making it an ideal choice for biopharmaceutical companies and academic institutions alike.
Faster Processing Time and Cost-Effectiveness
By optimizing antibody capture and reducing the number of purification steps, Protein A Chromatography Resin accelerates the overall workflow. This increased efficiency translates into cost savings, making it an attractive solution for research laboratories and commercial biomanufacturing facilities. Researchers looking to elevate their research can rely on this resin to streamline purification while minimizing material wastage and operational costs.
Advanced Applications of Protein A Chromatography Resin
In addition to standard antibody purification, Protein A Chromatography Resin is integral to various advanced applications in the biotech and pharmaceutical industries. These include:
· Therapeutic Antibody Production: The demand for monoclonal antibodies in treating diseases like cancer, autoimmune disorders, and infectious diseases continues to rise. Protein A chromatography ensures the production of highly pure antibodies essential for clinical applications.
· Diagnostics and Research: High-purity antibodies are crucial for developing diagnostic tools, ELISA assays, and other laboratory techniques that require reliable and reproducible results.
· Biosimilar Development: As biosimilars become a growing market, Protein A chromatography plays a critical role in ensuring that these biologic alternatives meet stringent regulatory and performance standards.
For more details, check over here for our full range of chromatography resins and how they can benefit your research.
Why Choose Lytic Solutions, LLC for Protein A Chromatography Resin?
Lytic Solutions, LLC is committed to providing cutting-edge solutions for antibody purification. Our Protein A Chromatography Resin is designed to enhance recovery rates, improve purity, and optimize efficiency. Here’s why our clients trust us:
· High-Performance Resin: Our resin offers superior binding capacity, ensuring maximum antibody recovery.
· Custom Solutions: We provide tailored solutions to meet the specific needs of academic researchers and biopharmaceutical manufacturers.
· Industry Expertise: With years of experience in bioprocessing and purification technologies, we deliver reliable and professional lab research solutions.
Optimizing Antibody Recovery: Best Practices
To maximize the benefits of Protein A Chromatography Resin, consider the following best practices:
Buffer Optimization: Ensure that the binding and elution buffers are optimized for pH and ionic strength to maintain antibody stability.
Proper Resin Regeneration: Regularly clean and regenerate the resin to extend its lifespan and maintain efficiency.
Temperature and Storage Conditions: Store the resin at appropriate conditions to preserve its performance over time.
Column Packing Techniques: Properly pack the resin in chromatography columns to prevent flow inconsistencies and maximize binding capacity.
Optimized Elution Strategies: Use gentle elution methods to avoid protein denaturation and maintain antibody functionality.
For a more in-depth guide, click here now to learn about our best practices for optimizing Protein A chromatography.
The Future of Antibody Purification with Protein A Chromatography Resin
As demand for high-quality antibodies continues to rise, advancements in chromatography technology are paving the way for even more efficient purification techniques. Protein A Chromatography Resin remains at the forefront of these innovations, offering superior recovery rates, enhanced purity, and streamlined scalability. Biopharmaceutical companies and researchers looking to get more information on the latest purification advancements can explore Lytic Solutions, LLC’s cutting-edge solutions.
If you are ready to optimize your antibody purification process, go right here to discover how our Protein A Chromatography Resin can revolutionize your workflow. Whether you need a high-performance resin for large-scale production or specialized solutions for academic research, we are here to support your journey toward scientific excellence.
For expert guidance and personalized solutions, contact us today and let our team help you achieve superior antibody recovery with the best chromatography resin available.
Original Sources: https://lyticsolutions.livepositively.com/how-protein-a-chromatography-resin-enhances-antibody-recovery/

Sign in to leave a comment.